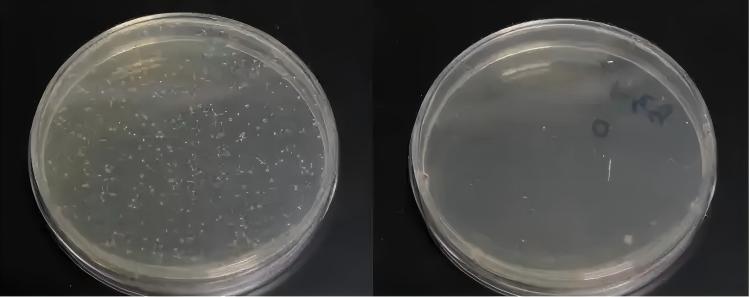
sterility-vs-cleaning-vs-disinfection-comparison

In a hospital injection room one morning, a nurse expertly tears open the packaging of a disposable syringe to administer insulin to a waiting patient. This seemingly routine action embodies one of modern medicine’s most fundamental safety principles: aseptic technique procedures. The sterility safety of every medical device used in healthcare infection prevention depends on rigorous protocols and unwavering attention to detail.
In today’s healthcare system, disposable hypodermic syringes have become one of the most basic and indispensable medical devices. Statistics show that over 16 billion disposable syringes are used globally each year—equivalent to more than two syringes per person on Earth. From a newborn’s first vaccine to a diabetic patient’s daily insulin injection, from hospital IV drips to community clinic intramuscular injections, syringes are everywhere, making injection safety protocols crucial.
Yet this seemingly simple medical tool—a thin needle, a transparent barrel, and a pushable plunger—conceals a critical safety element: sterility. A syringe that doesn’t meet sterile syringe standards can become a vector for deadly pathogens, transforming what should be therapeutic into a dangerous source of infection. Understanding disposable syringe sterility safety is essential for all healthcare professionals and patients.
In the 1980s, multiple countries experienced large-scale hepatitis B and C outbreaks due to inadequate syringe sterilization or reuse. In some regions, healthcare-associated infections accounted for over 40% of all new hepatitis cases. These painful lessons taught the medical community that syringe sterility isn’t an optional technical detail—it’s a safety red line that protects lives through proper healthcare infection prevention measures.
This article will take you deep into the importance of sterility in disposable hypodermic syringes, exploring the complete safety chain from the manufacturing floor to the patient’s skin, revealing the sophisticated science behind this small medical device and the critical role of injection safety protocols.
Chapter 1: What Is Medical Device Sterility?
The Scientific Definition of Sterility
Sterility, in the medical field, has an extremely strict and precise definition. It doesn’t mean “very clean” or “essentially bacteria-free”—it means the complete absence of any viable microorganisms, including bacteria, viruses, fungi, mycoplasma, chlamydia, and their spore forms. This is the foundation of disposable syringe sterility safety.
The word “complete” means absolute zero tolerance. Even if just one viable bacterial spore exists, the product cannot be called sterile. Consider this: under suitable conditions, a single bacterium can divide every 20 minutes, producing 16 million descendants after just 8 hours. So even one “escapee” could rapidly multiply in the human body and cause serious infection, undermining healthcare infection prevention efforts.
Sterility Assurance Level (SAL)
In actual production, proving that every single syringe is absolutely sterile is impossible—we can’t test every syringe without destroying the product. Therefore, international medical device sterilization standards introduced the concept of “Sterility Assurance Level” (SAL).
For invasive medical devices like disposable hypodermic syringes, international sterile syringe standards require an SAL of 10⁻⁶. What does this number mean? It indicates that among one million sterilized syringes, theoretically no more than one product could be contaminated. In other words, the probability of product contamination is less than one in a million.
How strict is this standard? For comparison, the aviation industry considers an accident rate of one in 100,000 to be unacceptably high risk. Medical device standards are ten times stricter than aviation safety standards, demonstrating the critical importance of disposable syringe sterility safety.
The Difference Between Sterility, Cleaning, and Disinfection
Many people confuse “sterility,” “cleaning,” and “disinfection,” but they have fundamentally different meanings in medicine and injection safety protocols:
Cleaning refers to removing dirt, organic matter, and some microorganisms from object surfaces. Like washing our hands daily, it can remove most dirt and microorganisms but can’t guarantee complete sterility. Cleaning is the foundation for all subsequent treatments, but it’s far from sufficient for healthcare infection prevention.
Disinfection refers to using chemical or physical methods to kill or remove most pathogenic microorganisms (but not bacterial spores) from object surfaces. Common disinfection methods include using alcohol, chlorine-based disinfectants, etc. Disinfection can achieve 95-99% bacterial killing effectiveness, but a small number of resilient microorganisms (especially spores) can still survive.
Sterilization is the highest level of treatment, aiming to kill all microorganisms, including the most resilient bacterial spores. Only products that have undergone medical device sterilization and passed strict testing can be called sterile products. This process is essential for maintaining sterile syringe standards.
For disposable hypodermic syringes, mere cleaning or disinfection is completely inadequate—they must achieve sterility. Because syringes penetrate the skin, directly delivering medication into body tissues or blood, any remaining microorganisms could cause infection, defeating healthcare infection prevention measures.
The Invisible Threat of Microorganisms
Why are we so particular about sterility in disposable syringe sterility safety? Because the microbial world is full of threats invisible to the naked eye.
A bacterial cell typically has a diameter of only 1-5 micrometers (1 micrometer = 0.001 millimeters), while viruses are even smaller at just 20-300 nanometers (1 nanometer = 0.000001 millimeters). On an area the size of a pinpoint, millions of bacteria could fit. Moreover, many pathogenic microorganisms have extremely strong survival capabilities:
- Bacterial spores can lie dormant in harsh environments for decades or even centuries, “reviving” once they enter suitable conditions
- Hepatitis B virus can survive in dried blood for over a week
- HIV, though fragile outside the body, can still survive in blood for several hours
- Staphylococcus aureus can produce multiple toxins that cause serious infection even in small quantities
Once these microorganisms enter the body through a syringe, they bypass the skin and mucous membranes—our natural barriers—reaching normally sterile tissues and blood. The consequences are unthinkable, which is why aseptic technique procedures are so critical.
Chapter 2: Why Is Sterility So Important for Injection Safety?
Breaching the Body’s Defenses

The human body is a complex ecosystem that has evolved multiple layers of defense mechanisms to resist pathogen invasion. The skin, as the outermost barrier, is the body’s first line of defense against microbial invasion. Intact skin is covered with a stratum corneum and sebum film, plus competitive inhibition from normal flora, preventing most pathogens from easily entering the body.
However, when a syringe needle penetrates the skin, this natural barrier is breached. The needle creates a channel approximately 0.4-0.8 millimeters in diameter, leading directly to subcutaneous tissue, muscle layers, or even inside blood vessels. This is why disposable syringe sterility safety and proper aseptic technique procedures are non-negotiable requirements.
Worse still, the injection process not only opens a channel but actively pushes substances into the body. If the syringe or medication is contaminated with microorganisms, these pathogens are injected directly into normally sterile tissues or blood, completely bypassing the body’s primary defense system. This is why injection safety protocols emphasize the critical importance of healthcare infection prevention.
Multiple Infection Risks
Infections caused using non-sterile syringes can be far more serious than most people imagine. These infections can be categorized into several levels:
Local Infection—The Starting Point of Danger
Local infection at the injection site is the most common and easily detected problem. When a contaminated syringe penetrates the skin, pathogenic microorganisms begin multiplying at the injection site, triggering a series of inflammatory responses:
- Redness, swelling, heat, and pain: The injection site shows erythema, swelling, warmth, and pain—signs of the immune system fighting pathogens
- Abscess formation: As infection progresses, local tissue dies, forming a pus-filled cavity. Abscesses may require surgical drainage
- Cellulitis: Infection rapidly spreads along subcutaneous loose connective tissue, forming large areas of redness and swelling with unclear borders, often accompanied by high fever
- Necrotizing fasciitis: In extreme cases, certain invasive bacteria (like streptococcus) can cause necrotizing fasciitis, a rapidly progressing, highly lethal severe infection that may require extensive debridement or even amputation
One diabetic patient, due to reusing syringes, developed an abscess at the injection site that spread into cellulitis, requiring three weeks of hospitalization for recovery. Such cases demonstrate why sterile syringe standards and healthcare infection prevention protocols must be strictly followed.
Systemic Infection—Body-Wide Threat
Even more frightening, if local infection isn’t controlled promptly, pathogens can enter the bloodstream, triggering systemic infection:
- Bacteremia and sepsis: Bacteria enter the blood and multiply, triggering a systemic inflammatory response. Patients experience high fever, chills, blood pressure drops, multiple organ dysfunction, with mortality rates of 20-40%
- Infective endocarditis: Blood-borne bacteria colonize heart valves, forming vegetations that can destroy valves and cause heart failure, often requiring cardiac surgery
- Septic arthritis: Bacteria reach joint cavities through blood, causing purulent joint infection and potentially permanent joint damage
- Osteomyelitis: Bone tissue infection, difficult to treat, often requiring long-term antibiotic therapy or surgery to remove lesions
- Meningitis and brain abscess: Bacteria invading the central nervous system can cause severe neurological sequelae or death
A real case: A hospital once had a batch of inadequately sterilized syringes that caused 12 patients to develop fever after injection, with three progressing to sepsis before being rescued. This incident exposed how any lapse in sterility control and injection safety protocols can lead to catastrophic consequences.
Bloodborne Disease Transmission—The Hidden Killer

Beyond bacterial infections, syringe reuse or contamination can transmit bloodborne diseases, which often have long latency periods and far-reaching harm:
- Human Immunodeficiency Virus (HIV): AIDS virus can be transmitted through contaminated syringes. While modern antiviral therapy can effectively control AIDS, it remains a disease requiring lifelong treatment
- Hepatitis B Virus (HBV): Extremely contagious—a pinprick-sized drop of blood may contain enough virus to cause disease. Chronic hepatitis B can lead to cirrhosis and liver cancer
- Hepatitis C Virus (HCV): No vaccine available for prevention; about 80% of infections become chronic, potentially leading to liver failure
- Other pathogens: Including Treponema pallidum (syphilis), Plasmodium (malaria), etc., can also be transmitted through contaminated syringes
World Health Organization data is shocking: globally, unsafe injections cause approximately 33 million new hepatitis B infections, 2 million hepatitis C infections, and 260,000 HIV infections annually. A significant proportion comes from improper syringe use in healthcare facilities, highlighting the critical need for disposable syringe sterility safety measures.
Vulnerability of Special Populations

The body’s immune system isn’t constant—resistance to infection varies greatly among different populations and physiological states. For certain special populations, even trace amounts of microorganisms can cause serious consequences, making aseptic technique procedures even more critical:
Newborns and Infants
Newborn immune systems are immature, lacking sufficient antibodies and immune cells. Passive immunity from the mother gradually disappears within months after birth, while active immunity hasn’t yet fully developed. During this “immune window period,” infants are highly susceptible to infection, and infections progress rapidly with severe symptoms.
A premature infant could develop sepsis from minor contamination during injection, requiring weeks of rescue in a neonatal intensive care unit. For these fragile lives, aseptic technique and disposable syringe sterility safety cannot tolerate any mistakes.
Elderly People
As people age, immune function gradually declines—a phenomenon called “immunosenescence.” T-cell and B-cell function decreases in the elderly, phagocytic cell activity drops, and infection response capability weakens. Additionally, many elderly people have chronic diseases like diabetes and cardiovascular disease, further increasing infection risk.
Clinical observations show that injection site infections of the same severity may be minor problems in young people but can rapidly deteriorate into systemic infection in the elderly, emphasizing the importance of healthcare infection prevention.
Immunosuppressed Patients
Certain diseases or treatments severely impair immune system function:
- Cancer chemotherapy patients: Chemotherapy drugs destroy normal white blood cells while killing cancer cells, leaving patients in a state of “neutropenia” with extremely high infection risk
- Organ transplant patients: To prevent rejection, they must use immunosuppressants long-term, artificially lowering immune defense capability
- AIDS patients: The virus directly attacks the immune system’s core—CD4+ T lymphocytes—making patients susceptible to various opportunistic pathogens
- Autoimmune disease patients: Patients with rheumatoid arthritis, lupus, etc., often need steroids and immunosuppressants to control disease, which also reduces infection resistance
For these patients, microorganisms that normally don’t cause disease can trigger fatal infections. Therefore, any injection procedure for them requires the highest sterile syringe standards and strictest injection safety protocols.
Diabetic Patients
Diabetic patients are one of the major user groups for syringes, potentially requiring multiple daily insulin injections. But diabetes itself increases infection risk:
- High blood sugar environments inhibit white blood cell function, reducing phagocytic and bactericidal capacity
- Diabetic patients often have vascular and neuropathic complications affecting wound healing
- Infection itself makes blood sugar harder to control, creating a vicious cycle
For diabetic patients, every injection is a potential infection opportunity—syringe sterility and proper injection technique must be ensured through adherence to aseptic technique procedures.
Pregnant Women
Pregnant women’s immune status undergoes subtle changes—to avoid rejecting the fetus (which has paternal genes making it “semi-allogeneic”), cell-mediated immunity is somewhat suppressed. This makes pregnant women more susceptible to certain infections. More importantly, maternal infections can affect fetal development, and some pathogens can cross the placenta to the fetus, causing congenital infection.
When injecting pregnant women, sterility requirements protect not only the mother but also the unborn baby, making disposable syringe sterility safety doubly important.
Chapter 3: Sterility Assurance System for Disposable Syringes
A qualified sterile syringe goes through a comprehensive quality control system from raw materials to final product. Every link in this system is crucial for maintaining disposable syringe sterility safety—any oversight could result in non-compliant products that compromise healthcare infection prevention.
Comprehensive Production Control
Clean Rooms—The Cradle of Sterility

Entering a disposable syringe production workshop, the first thing you notice is the environment’s stark difference from the outside world. This implements GMP (Good Manufacturing Practice) standards with strict requirements for air cleanliness, essential for medical device sterilization.
Production workshops typically need to meet Class 100,000 cleanroom standards, with critical process areas requiring Class 10,000 or higher. What is Class 100,000? It means no more than 352,000 dust particles ≥0.5 micrometers per cubic meter of air, and no more than 2,000 particles ≥5 micrometers. For comparison, ordinary outdoor air can contain millions or even tens of millions of particles per cubic meter.
To achieve this standard supporting sterile syringe standards, workshops are equipped with:
- High-efficiency air filtration systems (HEPA): Can filter 99.97% or more of particles ≥0.3 micrometers
- Positive pressure air supply systems: Workshop air pressure higher than outside, preventing contaminated air infiltration
- Unidirectional airflow design: Air flows from high-cleanliness areas to lower-cleanliness areas, avoiding cross-contamination
- Temperature and humidity control: Maintaining temperature 18-26°C, relative humidity 45-65%, ensuring product quality while inhibiting microbial growth
All personnel entering the workshop must undergo strict cleaning procedures following aseptic technique procedures:
- Remove daily clothing in the changing room
- Wear specialized clean garments, masks, caps, gloves, and shoe covers
- Pass through an air shower room where high-velocity clean air blows away surface dust
- Disinfect hands before entering production areas
The entire workshop implements strict separation of personnel and material flows, maximizing contamination source reduction for optimal disposable syringe sterility safety.
Strict Raw Material Selection

Syringe main components include barrel, needle, plunger, outer sleeve, etc. Each component’s material selection is carefully considered to meet sterile syringe standards:
Barrel and plunger typically use medical-grade polypropylene (PP) or polyethylene (PE). These materials must meet:
- Biocompatibility: Won’t cause tissue irritation or toxic reactions
- Chemical stability: Won’t react with drugs, won’t release harmful substances
- Transparency: Can clearly see medication inside the syringe
- Sterilization resistance: Can withstand high temperatures or radiation during medical device sterilization without deformation or degradation
Needles use medical stainless steel (typically 304 or 316L stainless steel), featuring:
- High strength: Can smoothly penetrate skin without bending
- Corrosion resistance: Won’t be corroded by medications or body fluids
- Sharpness: Needle tip precisely ground to reduce tissue damage and pain
- Smoothness: Inner and outer surfaces smooth, reducing injection resistance
Plunger rubber components typically use natural rubber or silicone rubber, requiring:
- Good elasticity: Provides excellent sealing
- Sliding performance: Smooth injection, uniform resistance
- Aging resistance: Long-term storage without hardening or cracking
- Non-toxicity: Contains no harmful plasticizers
All raw materials undergo strict inspection before production:
- Supplier qualification review and on-site audits
- Quality test report review for each batch of raw materials
- Sampling re-inspection after arrival
- Biocompatibility testing (cytotoxicity, sensitization, irritation)
- Chemical composition analysis
Only fully qualified raw materials can be released for use in disposable syringe manufacturing.
Precision Manufacturing Process

Modern syringe production is highly automated, reducing human factor interference and supporting injection safety protocols:
- Injection molding: Raw materials are heated and melted in clean injection molding machines, injected into precision molds. The entire process occurs in a closed environment
- Automatic assembly: Through automated production lines, needles, barrels, plungers, etc. are precisely assembled. Robotic operation avoids human contact with products
- Online inspection: Each syringe passes through automatic visual inspection systems checking dimensions, appearance, scale accuracy, etc. Non-compliant products are automatically rejected
- Pre-packaging inspection: Final manual sampling ensures no defective products enter the next stage
The entire production process achieves full recording and traceability—each batch of products has a unique batch number traceable to specific production dates, raw material batches, operators, etc., supporting disposable syringe sterility safety verification.
Sterilization—The Critical Step to Sterility
Syringes manufactured in clean environments can’t be called sterile products because even in Class 100,000 cleanrooms, small amounts of microorganisms still exist in the air. To achieve sterility and meet sterile syringe standards, professional sterilization treatment is necessary.
Ethylene Oxide (EO) Sterilization

This is the most commonly used medical device sterilization method for disposable syringes. Ethylene oxide is a cyclic organic compound with powerful penetration and bactericidal capabilities.
Sterilization process:
- Pretreatment: Place packaged syringes in sterilization chamber, vacuum and humidify to make product surfaces slightly moist (too low humidity affects sterilization effectiveness)
- Gas charging: Inject ethylene oxide gas, concentration typically 450-1000 mg/L, temperature controlled at 50-60°C
- Holding: Maintain these conditions for 2-6 hours. Ethylene oxide molecules penetrate every corner of the product, undergoing alkylation reactions with microbial proteins and nucleic acids, causing microbial death
- Aeration: After sterilization, vacuum to remove ethylene oxide gas, then introduce clean air for displacement—this process repeats multiple times
- Aeration storage: Products need placement in aeration rooms for 7-14 days for complete ethylene oxide dissipation. Ethylene oxide is toxic; residual levels must be below 10 ppm for safe use
EO sterilization advantages:
- Low-temperature sterilization, suitable for plastic products
- Strong penetration, can sterilize products inside packaging
- Minimal material damage
Disadvantages:
- Long cycle (including aeration time)
- Ethylene oxide is flammable and explosive, requiring specialized equipment and operation
- Some environmental impact
Gamma Radiation Sterilization

This is another important medical device sterilization method using gamma rays generated by radioactive isotope cobalt-60 to kill microorganisms.
Sterilization mechanism: Gamma rays are high-energy electromagnetic radiation that can directly damage microbial DNA molecules or generate free radicals through water molecule ionization, indirectly injuring microorganisms.
Sterilization process:
- Products conveyed via belt into irradiation room
- Products circulate around cobalt-60 source, receiving uniform irradiation
- Exit room after reaching specified radiation dose (typically 25-50 kGy)
- Entire process takes only hours, no aeration needed
Gamma irradiation advantages:
- Extremely strong penetration, can sterilize boxed final packaged products
- Room temperature sterilization, rapid process
- No chemical residues
- Can be used or shipped immediately after sterilization
Disadvantages:
- High-dose irradiation may cause some materials to discolor or change properties
- Requires specialized irradiation facilities, high investment
- Strict radioactive source management
High-Temperature Steam Sterilization
While plastic syringes aren’t suitable for high-temperature steam sterilization, glass syringes and certain heat-resistant metal components can still use this medical device sterilization method.
Typical steam sterilization conditions are 121°C for 20 minutes or 134°C for 3-4 minutes. High-temperature, high-pressure steam condenses on microbial surfaces, releasing large amounts of heat, causing protein coagulation and DNA denaturation, thereby killing microorganisms.
This is the most commonly used sterilization method in hospitals—advantages include speed, economy, no residue, but only usable for heat-resistant items.
Sterilization Effectiveness Validation

Every sterilization must undergo strict effectiveness validation to ensure disposable syringe sterility safety:
- Physical parameter monitoring: Record temperature, pressure, time, gas concentration, or radiation dose during sterilization, ensuring specified requirements are met
- Chemical indicators: Place chemical indicator cards in sterilization packaging; judge whether sterilization conditions are met by color changes
- Biological indicators (BI): Most reliable method. Use tubes containing highly resistant spores (like Bacillus stearothermophilus) sterilized with products. Culture after sterilization—if spores are killed (no growth in culture), sterilization is effective
- Sterility testing: Following pharmacopeia methods, sample sterilized products for sterility testing, confirming no microbial growth
Only batches passing all validations can be released for shipment, ensuring sterile syringe standards are met.
Sterile Packaging—The Final Defense
Sterilized syringes exposed to air quickly become recontaminated. Therefore, sterile packaging must immediately follow sterilization and maintain packaging integrity throughout storage and transportation to preserve disposable syringe sterility safety.
Packaging Material Selection

Syringe packaging typically uses medical-grade composite film composed of multiple layers:
- Outer layer: Polyester (PET) or nylon, providing mechanical strength and printing surface
- Middle layer: Aluminum foil, providing excellent barrier properties, preventing water, oxygen, and light penetration
- Inner layer: Polyethylene (PE), heat-seal layer, directly contacts product, non-toxic and harmless
This multilayer structure protects products from external contamination while maintaining packaging integrity over the shelf life (typically 3-5 years).
Packaging materials must meet sterile syringe standards:
- Microbial barrier properties: Blocks bacteria and viruses
- Physical strength: Tear-resistant, puncture-resistant, drop-resistant
- Chemical stability: Doesn’t react with products, doesn’t release harmful substances
- Sterilization compatibility: Can withstand sterilization without damage
- Seal reliability: Doesn’t leak after heat sealing
Strict Packaging Process Control
Packaging also occurs in cleanrooms following aseptic technique procedures:
- Automatic packaging: Sterilized syringes pass through automatic packaging machines for individual packaging. Machines place syringes in formed packaging bags, then heat-seal
- Seal integrity testing: Each completed package undergoes seal integrity testing. Common method: place package underwater, observe for bubbles under pressure
- Labeling printing: Print product information on packaging, including:
- Product name and specifications
- Production batch number and expiration date
- Sterilization method and batch number
- Manufacturer information
- Usage instructions and warnings
- Barcode or QR code (for traceability)
- Outer packaging: Place individually packaged syringes in cartons, also labeled with batch number, quantity, storage conditions, etc.
The entire packaging process implements strict environmental monitoring, regularly testing workshop air, work surface, and operator hand microbial contamination, ensuring packaging doesn’t introduce new contamination that would compromise disposable syringe sterility safety.
Quality Testing—Rigorous Gatekeeping
Each batch of syringes shipped undergoes a series of strict quality tests—this is the final checkpoint ensuring product sterility and compliance with sterile syringe standards.
Sterility Testing

This is the core testing project for disposable syringe sterility safety. Following Chinese Pharmacopoeia or United States Pharmacopeia methods:
- In clean sterility testing room, randomly sample products from each batch (typically no fewer than 20 units)
- Immerse samples in culture media (using thioglycollate medium and soybean casein digest agar medium), incubate at 30-35°C and 20-25°C for 14 days
- Observe whether culture media becomes turbid (bacterial growth). If all samples show no growth, the batch passes sterility testing
- If positive results occur, retesting is required. If retest still fails, the batch cannot be shipped
While this test can’t check every syringe, through scientific sampling methods, it can ensure entire batch sterility with high confidence.
Pyrogen Testing
Even if products are sterile, if they contain bacterial metabolites (endotoxins), injection can still cause fever reactions. Therefore, pyrogen testing is necessary for healthcare infection prevention.
Traditional method is the rabbit test: inject product extract into rabbit ear veins, observe temperature changes within 3 hours. If temperature rises more than 0.6°C, pyrogen is positive.
Modern practice more commonly uses the Limulus Amebocyte Lysate (LAL) test: utilizing the principle that limulus (a marine organism) blood cell lysate coagulates when encountering endotoxins, quickly detecting endotoxin content. Medical syringe endotoxin limits typically require less than 0.5 EU/ml.
Physical Performance Testing
Beyond sterility, syringe physical performance is also crucial for injection safety protocols:
- Scale accuracy: Use standard measuring tools to test syringe scale accuracy; error must be within allowable range (typically ±5%)
- Tightness: Pull syringe plunger to maximum scale, maintain pressure for 5 minutes, check for air leakage
- Sliding performance: Measure force required to push plunger; shouldn’t be too high (difficult injection) or too low (easy slippage)
- Needle firmness: Apply specified pulling or twisting force, check whether needle detaches
- Needle sharpness: Use specialized instruments to test force needed for needle to puncture silicone simulated skin, evaluating needle sharpness
- Residual volume testing: After injection completion, medication remaining in syringe should be minimal
Chemical Safety Testing
- Heavy metal detection: Detect lead, cadmium, etc. content, preventing material contamination
- Reducing substances: Detect reducing substances that might affect drug stability
- Easily oxidizable substances: Detect substances that might cause oxidation reactions
- Acidity/alkalinity: Detect pH of product extract
- UV absorbance: Detect abnormal UV absorption (indicating organic compound leaching)
Only products passing all test items can receive release authorization, be labeled as qualified, and enter circulation, ensuring disposable syringe sterility safety.
Full Cold Chain and Storage Management
Even properly manufactured sterile products can lose sterility if stored and transported improperly, compromising healthcare infection prevention efforts.
Storage Condition Requirements
- Temperature: Generally required storage at room temperature (15-30°C), avoiding high temperatures causing packaging material aging and seal degradation
- Humidity: Relative humidity should be controlled below 80%; excessive humidity may cause packaging dampness and mold
- Light: Avoid direct sunlight; UV rays may accelerate packaging material aging
- Ventilation: Storage areas should maintain ventilation and dryness, preventing mold growth
Warehouse Management
- Zoned storage, different batches and specifications stored separately
- Follow “first-in, first-out” principle, ensuring products are used within shelf life
- Regularly inspect inventory, promptly discovering damaged packaging and expired products
- Prevent rodent and insect damage, avoid packaging bites
Transportation Process Control
- Use specialized medical device transport vehicles
- Avoid severe jolting, heavy pressure, rain exposure
- Consider insulated vehicles during summer high temperatures
- Each transport has complete records including time, vehicle, temperature, etc.
Chapter 4: Aseptic Technique Procedures During Use
Even perfect sterile products can fail if used improperly. From opening the package to completing injection, every detail relates to injection safety and healthcare infection prevention.
Thorough Pre-Procedure Preparation
Environment Preparation
While achieving surgical room sterility is impossible, injection environments should be as clean as possible following injection safety protocols:
- Choose clean, dry, well-ventilated areas
- Wipe work surfaces with disinfectant (like 75% alcohol or chlorine disinfectant)
- Avoid operating in dusty or polluted air environments
- For home self-injection, can use dining tables, but clean surfaces beforehand
Hand Hygiene—The Most Important Step

Hands are the greatest contamination source during procedures. Even if hands look clean, surfaces still carry millions of microorganisms. Therefore, pre-injection hand cleaning is crucial for maintaining disposable syringe sterility safety.
Proper handwashing method (seven-step technique):
- Palm to palm, fingers together, rub against each other
- Palm to back of hand along finger gaps, alternate hands
- Palm to palm, fingers interlaced along gaps
- Bend finger joints, semi-fist position, rotate rubbing knuckles on opposite palm, alternate hands
- Grasp thumb with one hand, rotate rubbing, alternate hands
- Bend finger joints, fingertips together rotating in opposite palm, alternate hands
- Grasp wrist with one hand, rotate rubbing, alternate hands
Entire process uses running water and hand soap, minimum 30 seconds. Without handwashing facilities, can use alcohol-based hand sanitizer, rubbing until hands dry (about 20-30 seconds).
Package Inspection
Before opening packaging, must carefully check to ensure sterile syringe standards:
- Expiration date: Check expiration date marked on packaging; expired products absolutely cannot be used
- Package integrity: Carefully observe whether packaging has damage, pinholes, cracks. Can gently squeeze packaging to feel for leaks
- Appearance: Through packaging, observe syringe for stains, foreign matter, discoloration
- Batch number and markings: Confirm product information is clear and correct
If any abnormalities are found, the product must not be used, should be stored separately and reported to supplier, as this compromises disposable syringe sterility safety.
Injection Site Preparation

Injection site skin cleaning is equally important for healthcare infection prevention:
- Choose injection site: Select appropriate site based on injection type
- Subcutaneous injection: Outer upper arm, abdomen, outer thigh
- Intramuscular injection: Buttocks, outer thigh, deltoid muscle of upper arm
- Intravenous injection: Cubital fossa, dorsal hand veins
- Skin cleaning: Wipe injection site with 75% alcohol swab or iodophor swab, coverage diameter minimum 5 cm
- Disinfection method: Wipe from center outward in spiral pattern; don’t repeatedly wipe back and forth (avoids bringing peripheral bacteria to center)
- Wait to dry: After disinfection, must wait at least 30 seconds for disinfectant to fully work and naturally dry. Premature injection reduces disinfection effectiveness and may carry disinfectant into tissue causing irritation
Medication Preparation
If drawing medication using aseptic technique procedures:
- Check medication expiration date, clarity, for precipitation or discoloration
- Before opening ampule, disinfect bottle neck with alcohol swab
- After opening ampule, needle shouldn’t touch ampule exterior
- For rubber-stoppered medication vials, wipe rubber stopper with alcohol swab before puncturing
- When drawing medication, avoid producing bubbles; expel bubbles after drawing
Aseptic Technique During Procedure
Proper Handling Technique

Following injection safety protocols for disposable syringe sterility safety:
- Open packaging: Gently tear along marked tear line on packaging, avoiding excessive force causing syringe to pop out and contaminate
- Remove syringe: Can only touch plunger end and barrel exterior; absolutely cannot touch needle, inside of needle cap, or syringe front end
- Remove needle cap: Pull cap straight out, don’t rotate (may loosen needle)
- Verify medication: Reconfirm drug name, dosage, concentration
- Purge air: Point syringe needle upward, gently flick barrel to make bubbles rise, slowly push plunger to expel air. Note: when purging, prepare alcohol swab below needle tip to catch expelled medication and avoid splatter
- Tighten skin: Left hand tightens skin at injection site (for children and thin individuals, can pinch up skin)
- Insert needle:
- Subcutaneous injection: Rapidly insert at 30-40 degree angle
- Intramuscular injection: Rapidly insert vertically at 90 degree angle
- Intravenous injection: Insert along vein direction at 15-30 degree angle
- Aspirate: For intramuscular injection, after insertion, gently aspirate to confirm no blood return (indicating not in blood vessel) before pushing medication. If blood returns, withdraw and choose new site
- Push medication: Slowly and evenly inject medication. Too-fast speed may cause excessive local drug concentration, causing pain or tissue damage
- Withdraw needle: After injection completion, press injection point with alcohol swab, quickly withdraw needle. Continue pressing 2-3 minutes, avoiding bleeding or medication extravasation
Contamination Behaviors That Must Be Avoided
To maintain disposable syringe sterility safety and healthcare infection prevention:
- Touching needle or needle tip with hands: Hands are the greatest contamination source
- Needle contacting non-sterile surfaces: Like tabletops, clothing, non-disinfected skin
- Placing removed syringes randomly: Should keep needle pointing upward, avoiding contamination contact
- Re-capping needles: Easy to cause needle-stick injuries, and needle may already be contaminated
- Two syringes sharing one medication vial: Previous syringe may contaminate vial
- Talking while operating: Saliva droplets may contaminate sterile areas
Safe Disposal After Procedure
Injection completion doesn’t mean work is finished—safe waste disposal is equally important for injection safety.
The “Three Don’ts” Principle
- Don’t re-cap needles: This is the primary cause of needle-stick injuries among healthcare workers. When capping, if misaligned, needle easily punctures cap and stabs fingers
- Don’t manually break needles: Attempting to break needles may not only cause injury, but broken needles may bounce and injure people
- Don’t dispose carelessly: Used syringes mixed with household waste may injure sanitation workers or scavengers, and may be illegally recovered and reused
Proper Disposal Methods

Healthcare facilities:
- Immediately place in specialized sharps containers (yellow, lidded, puncture-resistant, marked with biohazard symbol) after use
- Stop using sharps containers when 3/4 full, seal
- Collected by professional medical waste disposal companies
- Centrally processed through high-temperature incineration or chemical disinfection
Home self-injection:
- Prepare rigid container (like detergent bottle, water bottle), place used syringe needle-down inside
- When full, tighten bottle cap, reinforce with tape, label “Medical waste, beware needle-stick”
- Deliver to community health service center or hospital medical waste collection point
- Never throw in household trash or drains
Special Considerations for Special Populations
For diabetic patients and others requiring long-term self-injection with disposable syringes:
- Only prepare one syringe for current use, don’t open multiple at once
- Establish injection rotation plan, avoid repeated injection at same site causing nodules or lipohypertrophy
- Record each injection’s site, time, dosage
- Regularly (at least annually) have healthcare professionals evaluate injection technique
- When hands have breaks or infections, pay special attention to hand hygiene, wear gloves if necessary
- Those with poor vision can use injection aids or ask family assistance
Chapter 5: Global Perspective—Injection Safety Challenges and Progress
Injection safety isn’t just a technical issue—it’s a global public health challenge. In different world regions, this problem presents starkly different faces, particularly regarding disposable syringe sterility safety.
Severe Situations Facing Developing Countries
The Vicious Cycle of Resource Scarcity
In many low-income countries, medical device resources are extremely scarce:
- Economic pressure: Though disposable syringes aren’t expensive (several cents to several yuan per unit), for financially struggling healthcare facilities and impoverished patients, it’s still a burden. To save costs, some places see syringe reuse
- Supply chain problems: Remote areas have poor transportation, medical supply delivery difficulties. Sometimes even with purchasing funds, timely adequate disposable syringes are hard to obtain
- Infrastructure deficiencies: Lack of reliable cold chain storage, sterilization equipment. Even if sterile products are purchased, they may become ineffective due to improper storage
Absence of Knowledge and Awareness
- Insufficient training: Grassroots healthcare workers may not have received systematic aseptic technique training, don’t understand injection safety importance
- Traditional concepts: Some regions have mistaken beliefs that “boiling disinfection is enough,” don’t understand the difference between sterility and disinfection
- Lack of patient education: Patients don’t know they have the right to demand use of new disposable syringes, don’t know how to protect themselves
Shocking Statistics
World Health Organization surveys show the critical need for improved healthcare infection prevention:
- Globally, about 16 billion injections annually, of which 40% (about 6.4 billion) use reused or inadequately disinfected syringes
- In some regions, over 50% of injections don’t meet injection safety protocols
- Unsafe injections annually cause approximately:
- About 1.7 million new hepatitis B infections
- About 315,000 new hepatitis C infections
- About 33,000 new HIV infections
- Deaths from unsafe injections reach 1.3 million annually
Behind these numbers are countless family tragedies. One seemingly insignificant injection may make someone a lifelong hepatitis virus carrier, highlighting the importance of disposable syringe sterility safety.
Specific Cases
In 2007, a developing country village experienced a large-scale hepatitis outbreak. Investigation found a “barefoot doctor” injecting villagers repeatedly used the same syringe, only rinsing with tap water between patients. Result: 89 people infected with hepatitis B, 12 developed chronic hepatitis.
Such tragedies repeatedly occur in many resource-poor regions, exposing injection safety problem severity and the need for proper sterile syringe standards.
Response Strategies and International Efforts
Facing severe challenges, the international community and governments are taking multiple measures to improve disposable syringe sterility safety:
Promotion of Auto-Disable Syringes

Auto-disable (AD) syringes are specially designed disposable syringes that automatically become unusable after one use:
- Self-locking mechanism: After injection, plunger automatically locks, can’t be pushed or pulled again
- Needle retraction: Some designs have needles automatically retract into barrel after injection, both preventing reuse and avoiding needle-stick injuries
- Destructive design: After use, plunger breaks or barrel deforms, clearly showing use
WHO strongly promotes such syringes, mandating use especially in vaccination programs. UNICEF purchases 100% auto-disable syringes for vaccines.
Though auto-disable syringes cost slightly more (about 20-30% more than regular syringes), considering infection costs avoided, they’re actually more economical and support healthcare infection prevention goals.
International Aid Programs

- Global Alliance for Vaccines and Immunization (GAVI): Provides funding to low-income countries to purchase safe syringes and injection safety equipment
- World Health Organization: Develops global injection safety guidelines, conducts training programs, monitors injection safety status in countries
- Bill & Melinda Gates Foundation: Invests in research and development of safer, cheaper syringe technology, supports injection safety projects
- Médecins Sans Frontières: Provides safe injection training and supplies in conflict zones and disaster areas
Policy and Legislation
Many countries strengthen injection safety and disposable syringe sterility safety through legislation:
- Mandatory use of disposable syringes: Laws clearly prohibit syringe reuse, violators face penalties
- Traceability systems: Each syringe has unique identification, traceable throughout production and distribution
- Medical waste management: Establish standardized medical waste collection, transportation, disposal systems
- Supervision and inspection: Health departments regularly or irregularly inspect healthcare facility injection operation standards
Education and Training
Healthcare worker training:
- Include injection safety in mandatory medical education curriculum
- In-service healthcare workers regularly attend injection safety training and assessment
- Develop online training courses and video materials for grassroots learning on aseptic technique procedures
Public education:
- Promote injection safety knowledge through media
- Conduct health education activities in communities
- Patient rights education: Inform patients they have right to demand new sterile syringes
Peer education: Train patient educators, having diabetic patients educate other patients on proper injection technique and disposable syringe sterility safety.
Ongoing Challenges in Developed Countries
Even in medically resource-rich developed countries, injection safety faces new challenges:
Healthcare-Associated Infection Events
Though probability is low, shocking healthcare-associated infection events still occasionally occur, compromising healthcare infection prevention:
- 2008: A U.S. clinic reused disposable syringes to draw anesthetic drugs, exposing 114 people to hepatitis C virus risk, ultimately confirming 40 infections
- 2013: A national hospital had a nurse improperly operate (didn’t change needles when drawing from same medication vial for multiple patients), causing 8 hepatitis C infections
Most events aren’t equipment problems but human negligence—violating injection safety protocols, taking shortcuts for convenience, taking chances. This shows that even the best equipment is useless without standardized operations and strict supervision.
Risks for Substance Abusers
Injection drug users often share syringes, becoming high-risk populations for bloodborne disease transmission:
- Many countries implement “needle exchange programs”: Provide sterile syringes free to injection drug users, collect used syringes, reducing sharing behavior
- Controversy and ethical dilemmas: Some believe this condones drug use, but public health experts consider reducing disease transmission a more urgent goal
Occupational Risk of Needle-Stick Injuries
Healthcare workers face occupational exposure risk from needle-stick injuries:
- U.S. sees about 600,000-800,000 needle-stick injuries annually, considerable proportion involving infected patient needles
- After needle-stick injury, need viral testing, prophylactic medication, causing psychological stress and economic burden
- Promoting safety syringes (automatic needle retraction or protective shields) can significantly reduce needle-stick injuries
Chapter 6: Technological Innovation—A Safer Future
Technological progress is bringing revolutionary changes to injection safety and disposable syringe sterility safety. Next-generation syringes are not only safer but also smarter and more user-friendly.
The Rise of Smart Syringes
Anti-Misuse Features
Modern smart syringes integrate multiple anti-misuse designs supporting injection safety protocols:
- One-time locking: Automatically locks after use, plunger can’t be drawn or pushed again
- Timestamp recording: Built-in chip records usage time, automatically expires if timed out
- Dosage locking: After preset dosage, can’t adjust, preventing medication errors
- Dual-person verification: Some syringes for high-risk drugs require two people to simultaneously confirm before unlocking
Smart Monitoring and Traceability
RFID/NFC chips: Each syringe has built-in radio frequency identification chip recording full product lifecycle information:
- Production date, batch number, sterilization date
- Factory inspection data
- Distribution pathway (manufacturer → distributor → healthcare facility)
- Usage records (who used, when used, for which patient)
Such traceability systems, once quality problems are found, can quickly locate problem batches, timely recall, notify all patients who contacted that batch, ensuring disposable syringe sterility safety.
Anti-counterfeiting verification: Patients or healthcare workers scan QR codes or NFC tags with phones to verify product authenticity, check expiration dates, etc., effectively preventing counterfeit products from entering market
Usage Reminder Functions
For chronic disease patients requiring regular injections (like diabetes, growth hormone deficiency):
- Smart injection pens: Automatically record each injection’s time, dosage
- Phone app connection: Data syncs to phone, generates injection logs, reminds of next injection time
- Dosage calculation: Based on patient blood sugar level or weight, recommends injection dosage
- Injection site reminder: Rotates injection sites, avoids frequent use of same location causing lipohypertrophy
This intelligence not only improves medication compliance but also helps doctors remotely monitor patient treatment and injection safety.
Safety Needle Technology
Automatic Retractable Needles
After injection completion, needle automatically retracts into barrel interior and locks:
- Prevents needle-stick injuries: Healthcare workers won’t be stabbed when handling used syringes
- Prevents reuse: After needle retracts, can’t be used again, maintaining disposable syringe sterility safety
- Safe disposal: Retracted syringes are safer, reducing medical waste handler risk
Currently multiple trigger mechanisms exist:
- Plunger-triggered: After injection completion, continue pushing plunger to trigger retraction mechanism
- Button-triggered: After injection, press button, needle retracts
- Auto-triggered: Syringe senses plunger bottoming, automatically retracts
Protective Shield Design
Movable protective shield added outside needle:
- Push shield open before injection, needle exposed
- After injection, release hand, shield automatically returns under spring force, covering needle
- After shield locks, can’t be opened again, completely eliminating needle-stick injury risk
This design maintains traditional syringe usage habits while adding important safety protection for injection safety protocols.
Blunt Needle Technology
For certain special purposes (like drawing medication from rubber-stoppered vials), blunt needles developed:
- Needle tip is blunt and round, can penetrate rubber stopper but difficult to pierce skin
- Use blunt needle when drawing medication, change to sharp needle when injecting
- Reduces accidental needle-stick injuries during medication drawing
Needle-Free Injection Technology—The Future Direction
Needle-free injectors represent a revolutionary breakthrough in injection technology, fundamentally eliminating all needle-related risks while maintaining sterility.
Working Principle
Needle-free injectors utilize high-pressure jet technology:
- Pressure generation: Generate high pressure through springs, compressed gas, or electromagnetic force
- Micro liquid stream: Medication jets from tiny orifice (diameter about 0.15-0.25mm) under high pressure (typically 200-300 bar)
- Skin penetration: Liquid stream at extremely high speed (100-200 m/s) penetrates skin stratum corneum
- Drug diffusion: Drug forms depot in subcutaneous or muscle layer, gradually absorbed
Clear Advantages
- Zero needle-stick injury risk: No needle, completely avoids healthcare worker and patient needle-stick injuries
- Reduces cross-infection: Change nozzle each use, reduces infection transmission risk supporting healthcare infection prevention
- Reduces pain: Many patients report pain significantly lower than traditional needle injection
- Improves compliance: Especially children and needle-phobic patients more easily accept
- Improves drug absorption: Drug disperses more uniformly in tissue, absorption may be better
Current Applications
- Vaccination: Influenza vaccine, measles vaccine, etc.
- Insulin injection: Daily treatment for diabetic patients
- Growth hormone therapy: Children with growth hormone deficiency
- Aesthetic medicine: Hyaluronic acid, botulinum toxin injection, etc.
Facing Challenges
- Higher cost: Equipment prices are tens to hundreds of times traditional syringes
- Technical requirements: Need training for proper use with aseptic technique procedures
- Application scope: Not suitable for all drugs and all injection sites
- Equipment maintenance: Requires regular cleaning and maintenance
Nevertheless, with technological progress and large-scale production, needle-free injection technology promises wider future application.
Microneedle Patches—Gentle Revolution
Microneedle patches are another exciting innovation direction for injection safety.
Structure and Principle
Microneedle patches consist of hundreds of tiny needle-like projections, each microneedle only 0.5-1.5 millimeters long:
- Material selection: Dissolvable polymers, biodegradable materials, or metals
- Drug loading method: Drug can be coated on needle tips, embedded in needle body, or released from patch base after puncture
- Usage method: Press patch on skin, microneedles penetrate stratum corneum but don’t touch nerve endings
- Drug release: Microneedles dissolve or diffuse through skin channels, delivering drug into body
Unique Advantages
- Completely painless: Needle length insufficient to stimulate pain receptors
- Self-administration: Simple design, patients can use themselves without professional training
- Good stability: Drug exists in solid form, no cold chain storage needed
- No medical waste: Dissolvable microneedles completely biodegrade, no sharps waste
- Improves compliance: Convenient use, especially suitable for chronic disease management requiring frequent dosing
Research Progress
Currently multiple microneedle patches entering clinical trial stages:
- Influenza vaccine microneedle patch: Completed multiple clinical studies, immune effect equivalent to or better than traditional injection
- Measles-rubella vaccine patch: Trials in developing countries, promises to simplify vaccination procedures
- Insulin microneedle patch: Provides painless dosing option for diabetic patients
- Biologic patches: For rheumatoid arthritis, psoriasis, and other autoimmune disease treatment
Future Prospects
Microneedle patch technology represents a paradigm shift in drug delivery, from “active injection” to “passive application.” With advances in materials science, nanotechnology, and pharmaceutical formulation technology, microneedle patches promise to become routine medical devices within 5-10 years.
Smart Monitoring Systems
Internet of Things and artificial intelligence technologies are changing syringe management and disposable syringe sterility safety.
Full Process Tracking
- Production traceability: Complete records of each syringe from raw materials to finished product
- Logistics monitoring: Real-time monitoring of temperature, humidity, vibration, and other environmental parameters during transportation
- Inventory management: Smart warehousing systems within healthcare facilities, automatic warnings for near-expiry products and low stock
- Usage records: Scan code to register usage information, linked to patient electronic medical records
Data Analysis
Through big data analysis, can:
- Predict demand: Predict syringe demand based on historical data and seasonal factors
- Quality monitoring: Timely discover abnormal batches or quality trends
- Adverse event warning: Quickly identify potential safety issues
- Optimize supply chain: Reduce waste, lower costs
Blockchain Technology Application
Introducing blockchain technology to medical device management:
- Anti-counterfeiting verification: Each transaction node has tamper-proof records, effectively preventing counterfeit products
- Transparent traceability: Complete pathway from manufacturer to patient clearly visible
- Smart contracts: Automatically execute recall, compensation, and other processes
- Data security: Decentralized storage, protects patient privacy
Chapter 7: Regulation and Responsibility—Multiple Parties Building Safety Defense
Ensuring sterility safety of disposable hypodermic syringes requires joint efforts from regulatory agencies, manufacturing companies, healthcare facilities, and patients.
The Role of Regulatory Agencies
National drug regulatory agencies bear important responsibilities for safeguarding public health and disposable syringe sterility safety.
Market Access Management
In China, disposable syringes are Class II medical devices requiring registration certificates before marketing:
- Registration testing: Products sent to designated testing institutions for comprehensive testing including sterility verification
- Clinical evaluation: Provide clinical trial data or comparative studies with marketed products
- System inspection: Manufacturing companies must pass GMP (Good Manufacturing Practice) certification
- Technical review: Evaluate product safety and effectiveness
- Registration certification: Issue medical device registration certificate after approval
FDA in the U.S., CE in Europe, etc., also have similarly strict approval procedures ensuring sterile syringe standards.
Post-Market Surveillance
Product market approval isn’t the endpoint—regulation is an ongoing process for injection safety:
Unannounced inspections:
- Surprise inspections without prior notice
- Inspect production sites, quality records, warehousing logistics, etc.
- Can immediately halt production for rectification upon discovering serious violations
Adverse event monitoring:
- Establish medical device adverse event reporting system
- Healthcare facilities, companies, and individuals can report
- Analyze adverse event trends, identify potential risks
Sampling monitoring:
- Regularly sample products from market for testing
- Publish test results, expose non-compliant products
- Penalize and recall non-compliant products
Risk warnings:
- Issue safety risk alerts
- Guide healthcare facilities and public in proper use
- Launch emergency response in urgent situations
International Cooperation
Medical device safety is a global issue; regulatory agencies strengthen cooperation:
- Information sharing: Exchange adverse event information, inspection results
- Standards harmonization: Promote international standard unification for sterile syringe standards
- Mutual recognition agreements: Simplify redundant cross-border product approvals
- Joint actions: Combat cross-border counterfeit products
Corporate Responsibility
As product manufacturers, companies bear primary responsibility for disposable syringe sterility safety.
Quality Management System
Excellent medical device companies establish comprehensive quality management systems:
Design and development control:
- Adequate design verification and validation
- Risk management throughout design process
- Strict control of design changes
Supplier management:
- Audit supplier qualifications and capabilities
- Sign quality agreements
- Regular evaluation and on-site audits
- Multi-sourcing of key raw materials, avoiding single dependence
Production process control:
- Development and execution of Standard Operating Procedures (SOPs) following aseptic technique procedures
- Online monitoring of critical processes
- Isolation and handling of non-conforming products
- Regular maintenance and calibration of production equipment
Product inspection:
- Incoming inspection, in-process inspection, finished product inspection
- Retention sampling and stability studies
- Regular inspection capability verification for sterility
Traceability:
- Establish complete batch records
- Clear product identification, accurate information
- Can quickly locate problem products
Continuous Improvement
Excellent companies aren’t satisfied with compliance—they pursue excellence in disposable syringe sterility safety:
- Customer feedback: Collect opinions from healthcare facilities and patients, continuously improve products
- Technological innovation: Invest in R&D, develop safer, more user-friendly products
- Quality culture: Cultivate company-wide quality awareness, make quality everyone’s responsibility
- Industry leadership: Proactively adopt internal standards higher than regulatory requirements
Social Responsibility
Excellent companies also bear broader social responsibilities:
- Accessibility: Make safe products available to more people at reasonable prices
- Public welfare projects: Donate products to impoverished areas, disaster zones
- Education and training: Help grassroots healthcare workers improve injection safety awareness
- Environmental responsibility: Use environmentally friendly materials, optimize production processes to reduce pollution
Healthcare Facility Responsibility
Hospitals and clinics are the frontline of syringe use and healthcare infection prevention.
Standardized Procurement
- Qualification review: Only purchase from qualified legitimate channels
- Quality priority: Can’t pursue low prices alone, must comprehensively consider quality and sterile syringe standards
- Acceptance inspection: Upon delivery, check product certificates, test reports, package integrity
- Storage management: Store according to required conditions, regular inspection, first-in first-out
System Building
Establish sound management systems for injection safety protocols:
- Injection operation standards: Develop detailed standard operating procedures
- Aseptic technique requirements: Clarify specific requirements for aseptic operations
- Single-use regulations: Strictly prohibit reuse of disposable devices
- Medical waste management: Standardize collection, temporary storage, handover procedures
Personnel Training
- Pre-job training: New employees must undergo injection safety training and pass assessment
- On-job training: Regularly organize continuing education, update knowledge on aseptic technique procedures
- Skills assessment: Regularly evaluate operational skills, retrain those who fail
- Safety education: Strengthen safety awareness, eliminate taking chances
Infection Surveillance
Establish hospital infection surveillance system:
- Active surveillance: Regularly investigate injection-related infection incidence
- Reporting system: Timely report adverse events and infection cases
- Root cause analysis: Deeply analyze infection causes, plug loopholes
- Improvement measures: Develop corrective measures targeting problems and track effectiveness
Supervision and Inspection
Internal quality control within hospitals:
- Daily inspections: Head nurse, department director daily rounds
- Special inspections: Hospital infection management department special supervision
- Cross-inspections: Mutual inspections between different departments
- Patient supervision: Encourage patient participation in supervision, establish complaint channels
Patient Rights and Responsibilities
Patients are both recipients of medical services and participants and supervisors of injection safety.
Right to Information
Patients have the right to know about disposable syringe sterility safety:
- Devices used: Syringe brand, specifications, expiration date
- Operator qualifications: Name and credentials of person performing injection
- Possible risks: Potential adverse reactions from injection
- Precautions: Matters requiring attention before and after injection
Right to Choose
Within reasonable limits, patients have right to choose:
- Healthcare facilities: Choose facilities with good reputation and conditions
- Treatment plans: Choose suitable option among multiple plans
- Refuse improper operations: Have right to refuse when discovering violations of injection safety protocols
Right to Supervise
Patients can supervise medical processes:
- Observe operations: Note whether healthcare workers use new sterile syringes
- Check packaging: Can request to see whether syringe packaging is intact before injection
- Raise questions: Have right to question suspicious situations
- Lodge complaints: Report to hospital or regulatory departments when discovering serious problems
Cooperation Responsibility
Patients also need to bear corresponding responsibilities:
- Truthful disclosure: Inform doctor of allergy history, medication history, and other important information
- Follow medical advice: Use medication and care properly according to doctor’s orders
- Safe storage: Properly store syringes during self-injection
- Proper disposal: Dispose of used syringes according to regulations
Self-Protection
Patients should learn to protect themselves regarding disposable syringe sterility safety:
- Learn knowledge: Understand basic injection safety knowledge
- Stay vigilant: Carefully observe when seeking medical care
- Timely feedback: Promptly inform doctor of abnormal situations
- Rational rights protection: Resolve problems through proper channels when encountering issues
Chapter 8: Case Studies—Lessons and Insights
Historical infection events and excellent practices provide valuable lessons about injection safety and healthcare infection prevention.
Warning Cases
Case 1: Romanian AIDS Tragedy (1990s)
Event details: During Ceaușescu’s rule in Romania, due to scarce medical resources, syringe reuse was serious. In children’s hospitals and orphanages, one syringe would be repeatedly used multiple times, only rinsed with tap water.
Catastrophic consequences:
- Early 1990s, Romania discovered large numbers of HIV-infected children
- Confirmed about 10,000 children with healthcare-associated HIV infection
- Many children simultaneously infected with hepatitis B and C
- Became one of the world’s most serious healthcare-associated AIDS transmission events
Profound lessons:
- Economic difficulties cannot excuse ignoring disposable syringe sterility safety: Even with limited resources, must ensure basic medical safety
- Importance of training and education: Many healthcare workers didn’t understand injection safety importance
- Necessity of policy support: Government must provide necessary resources and institutional safeguards for medical safety
Case 2: U.S. Nevada Hepatitis C Outbreak (2008)
Event details: A Las Vegas, Nevada outpatient clinic, to save costs, adopted wrong operational practices violating injection safety protocols:
- Used disposable syringes to draw anesthetic drugs from shared vials for different patients
- Though each patient used new syringe, needle aspiration brought patient blood into shared vial
- This “one vial, multiple uses” practice continued for years
Serious consequences:
- About 77,000 patients notified of possible bloodborne pathogen exposure
- Confirmed 77 hepatitis C infections, tracing confirmed relation to clinic operations
- Clinic closed, related responsible parties prosecuted
- Patients received millions in compensation
Important insights:
- Seemingly safe operations may hide risks: “One needle per person” isn’t enough, must be “one needle, one syringe, one vial, one use per person”
- Can’t be penny-wise and pound-foolish: Taking huge risks to save small amounts of medication, not worth it
- Standard procedures don’t permit variation: Any “simplification” deviating from aseptic technique procedures may bring serious consequences
Case 3: Chinese “Hepatitis Village” Incident (Early 2000s)
Event background: Certain rural areas conducted paid blood donation in the 1990s; some illegal blood stations to improve collection efficiency:
- Multiple people shared blood collection needles
- Mixed blood from multiple people, separated plasma, then transfused red cells back
- Inadequate syringe disinfection or no disinfection at all
Tragic results:
- Thousands of blood donors infected with HIV, hepatitis B, hepatitis C
- Formed multiple “AIDS villages,” “hepatitis villages”
- Many families impoverished by disease, children became orphans
- Social impact continues today
Painful reflections:
- Serious consequences of regulatory absence: Illegal medical practice must be severely cracked down
- Economic interests cannot override life safety and disposable syringe sterility safety
- Prevention beats treatment: Post-event treatment and assistance far inferior to prevention
Excellent Practices
Case 1: WHO Safe Injection Global Network (SIGN)
Project content: World Health Organization established Global Safe Injection Network promoting injection safety improvements globally:
Strategic measures:
- Develop “Injection Safety Policy” guidance documents
- Promote auto-disable syringes, especially in vaccination
- Conduct large-scale training programs on aseptic technique procedures
- Establish injection safety monitoring systems
Significant achievements:
- 2000-2010, unsafe injection proportion dropped from 39% to 5%
- Estimated avoidance of millions of hepatitis cases and tens of thousands of AIDS infections
- Multiple countries achieved 100% use of auto-disable syringes for vaccination
Success factors:
- Global cooperation: Government, international organizations, companies, NGOs participate together
- Tailored to local conditions: Develop suitable strategies according to different country situations
- Sustained investment: Long-term financial and technical support
- Effect evaluation: Regular monitoring and evaluation, timely strategy adjustments
Case 2: Singapore Healthcare Facility Zero-Tolerance Policy
Strict management: Singapore healthcare facilities implement zero-tolerance policy for injection safety and disposable syringe sterility safety:
Institutional measures:
- All injection operations have standard procedures following injection safety protocols, must strictly execute
- Implement “Five Ones” principle: One needle, one syringe, one vial, one use, one disinfection per person
- Establish strict accountability mechanism, violators face severe penalties
- Patient complaint channels open, hospitals must promptly investigate and respond
Technical means:
- Syringes use barcode management, scan code records usage information
- Operating rooms, injection rooms install monitoring systems
- Regularly conduct infection rate surveys and international benchmarking
Remarkable effects:
- Hospital infection rates remain extremely low (<2%)
- Almost no injection-related serious infection events
- High patient satisfaction and trust
- Became international medical safety benchmark
Lessons learned:
- Strict system execution: Best system without execution is just paper
- Technical means assistance: Use technology to solidify processes, reduce human error
- Culture shaping: Cultivate safety culture pursuing excellence in healthcare infection prevention
Case 3: Diabetic Patient Education Program
Program background: Diabetic patients need long-term self-injection of insulin; proper injection technique is crucial for disposable syringe sterility safety.
Education content: Many countries conduct systematic patient education programs:
- Knowledge education: Why ensure sterility, infection risks and consequences
- Skills training: Hand cleaning, skin disinfection, injection technique, syringe disposal following aseptic technique procedures
- Psychological support: Overcome injection fear, build confidence for long-term persistence
- Follow-up guidance: Regularly evaluate injection technique, discover and correct errors
Innovative methods:
- Develop phone apps providing video tutorials and medication reminders
- Establish patient mutual support groups for experience sharing and mutual support
- Provide phone consultation hotlines, timely answer questions
- Cooperate with community health service centers, provide nearby guidance
Positive results:
- Patient injection technique pass rate significantly improved (from 60% to over 90%)
- Injection-related complications (infection, lipohypertrophy, blood sugar fluctuation) significantly reduced
- Patient treatment compliance and quality of life improved
- Reduced medical visits and hospitalization due to complications
Scalable value:
- Patients are important safety participants: Empower patients, make them guardians of their own injection safety
- High return on education investment: Though requires education resources, long-term greatly reduces medical costs
- Technology-assisted education: Use modern information technology to improve education accessibility and effectiveness
Conclusion: Building Safety Defense Together, Protecting Life and Health
The disposable hypodermic syringe, this seemingly simple medical device, carries the foundation of modern medical safety. From microorganisms invisible under microscopes to public health systems affecting millions, sterility is the lifeline running throughout, making disposable syringe sterility safety a paramount concern.
Sterility: The Uncompromising Baseline
We’ve seen that:
- Scientific rigor: Sterility isn’t “pretty clean” but absolute zero tolerance; the 10⁻⁶ sterility assurance level represents reverence for life
- Serious risks: One seemingly harmless violation of injection safety protocols may cause serious infection or even deadly disease transmission
- Great responsibility: From regulators to manufacturers, from healthcare workers to patients themselves, every link in maintaining disposable syringe sterility safety tolerates no negligence
Technology: Hope Brought by Innovation
Technological progress brings new possibilities for injection safety and medical device sterilization:
- Smart traceability: Give every syringe an “ID card,” full process trackable
- Safety design: Automatic retractable needles, anti-misuse mechanisms—use technology to eliminate human error
- Needle-free injection and microneedle patches: Fundamentally eliminate all needle-related risks while maintaining sterility
- Artificial intelligence and big data: Warn of risks, optimize management, make safety systems smarter for better healthcare infection prevention
Responsibility: Shared Mission
Injection safety and disposable syringe sterility safety is everyone’s responsibility:
- Regulatory agencies: Strict market access, strengthened post-market surveillance, maintained regulatory authority for sterile syringe standards
- Manufacturing companies: Pursue quality through rigorous medical device sterilization, continuous innovation, fulfill social responsibilities
- Healthcare facilities: Standardized procurement, rigorous training in aseptic technique procedures, strict supervision
- Patients: Know rights, learn to protect selves, actively participate in safety monitoring
Looking Forward: Toward a Safer Future
With global cooperation deepening, technology continuously advancing, safety awareness strengthening, we have reason to believe:
- Safer, smarter syringes meeting the highest sterile syringe standards will become standard
- Injection safety education will reach every corner
- Monitoring systems will be more complete, responses more rapid
- Injection-related infections will continue to decline through better healthcare infection prevention
But we must always remember: behind every syringe is a living life, every injection is a commitment to patient trust. Only when all participants keep sterility and safety in mind, following strict aseptic technique procedures and injection safety protocols, can we truly build an impregnable injection safety defense line.
Safety first, life paramount. This is our unchanging commitment to disposable syringe sterility safety, and the future we pursue together.
Key Takeaways for Disposable Syringe Sterility Safety
Essential Points to Remember:
- Sterility means complete absence of all microorganisms—not just “clean” but absolutely pathogen-free
- Disposable syringes must meet SAL 10⁻⁶ standard (less than one contaminated unit per million)
- Proper medical device sterilization methods include EO gas, gamma radiation, and steam autoclaving
- Aseptic technique procedures are critical from package opening to final disposal
- Injection safety protocols require strict adherence at every step to ensure healthcare infection prevention
- Sterile syringe standards protect vulnerable populations: newborns, elderly, immunocompromised patients
- Every healthcare professional and patient plays a vital role in maintaining disposable syringe sterility safety
Resources for Further Learning:
- World Health Organization Injection Safety Guidelines
- CDC Healthcare Infection Control Practices
- National regulatory agency medical device safety resources
- Professional training on aseptic technique procedures
- Patient education materials on safe self-injection
By understanding and implementing these principles of disposable syringe sterility safety, we collectively contribute to a safer healthcare environment for all.




